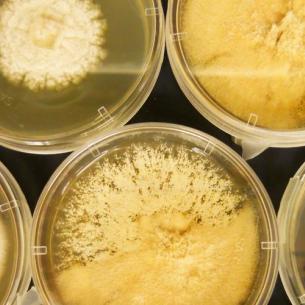

Micro-organismen
Bacteriën, virussen, eencellige algen en microscopisch kleine diertjes zijn allemaal piepklein maar hebben verder weinig met elkaar gemeen. Hoe klein ze ook zijn , ze spelen een grote rol op aarde. Micro-organismen hebben de grootste invloed op het zuurstofgehalte in de lucht en de zee. Het zijn de belangrijkste opruimers in de natuur: Ze breken dode planten en dieren af tot opnieuw bruikbare bouwstoffen, zowel in de zee en op het land.